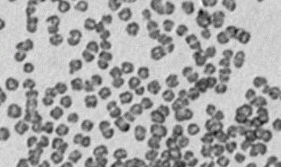
铋纳米球

氨基/羧基修饰/偶联/接枝/功能化铋纳米球 NH2/COOH-Bi nanosphere 的理化性质以及相关产品
发布时间:2022-07-28     作者:zyl   分享到:
金属铋为有银白色(粉红色)到淡黄色光泽的金属,质脆易粉碎;室温下,铋不与氧气或水反应,在空气中稳定。导电导热性差
氨基(Amino)由一个氮原子和两个氢原子构成,化学式为-NH2。在有机化学中,氨基是基本碱基,大多数含有氨基的有机物都有碱的特性
产品名称:氨基修饰铋纳米球 NH2-Bi nanosphere
产品形态:分散液或冻干粉
产品规格描述(浓度,尺寸,规格):30, 50, 100 nm
能提供的表征:扫描电镜,透射电镜
能提供的修饰:氨基、羧基、PEG、蛋白、抗体偶联
激发波长和发射波长:可定制
用途:填充剂、润滑剂、制造模板、药物载体等
西安齐岳生物科技有限公司是一家从事原料药、MOF,离子液体 ,PEG衍生物、科研试剂、多肽、光电材料、碳纳米管、纳米材料、脂质体、合成磷脂的研发、定制合成、生产和销售的高科技生物科技有限公司
相关产品:
铋纳米球 Bi nanosphere
氨基修饰铋纳米球 NH2-Bi nanosphere
羧基修饰铋纳米球 COOH-Bi nanosphere
PEG功能化铋纳米球 PEG-Bi nanosphere
蛋白修饰铋纳米球 Protein-Bi nanosphere
抗体偶联铋纳米球 antibody-Bi nanosphere
状态:固体/粉末/溶液
产地:西安
储存时间:1年
保存:冷藏
用途:科研
厂家:西安齐岳生物科技有限公司




齐岳微信公众号
官方微信
库存查询